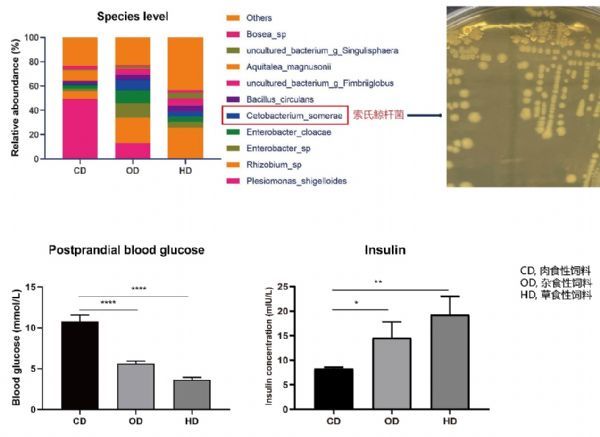

近日,中国农业科学院饲料研究所水产动物饲料创新团队发现鱼类肠道菌群中存在的一种高丰度菌——索氏鲸杆菌(Cetobacterium somerae),其可通过代谢产物乙酸激活副交感神经系统,从而促进鱼类胰岛素表达和糖利用能力,对鱼体健康起重要调控作用。相关研究成果发表在《肠道微生物(Gut Microbes)》上。
据团队首席周志刚研究员介绍,鱼类利用糖的能力普遍偏低,提高养殖鱼类的糖利用能力具有非常重要的现实意义和经济价值,是水产学研究的国际前沿和热点课题。动物肠道菌群对宿主的糖代谢起重要调控作用,但鱼类肠道菌群发挥调控功能的作用机制尚不清楚。
该研究发现斑马鱼体糖利用能力的差异由肠道菌群介导,且与肠道中索氏鲸杆菌的丰度呈极显着正相关。研究确认索氏鲸杆菌能够促进斑马鱼胰岛素表达,从而降低血糖。索氏鲸杆菌的主要代谢产物——乙酸是促进斑马鱼胰岛素表达并降低血糖的重要因子。进一步研究发现,索氏鲸杆菌和乙酸均可通过副交感神经系统调控激活胰岛素表达,促进鱼体糖利用能力。该研究发现的索氏鲸杆菌及其对糖代谢的调控为改善鱼类糖利用能力提供了新的思路,可促进开发基于鲸杆菌及其相关益生元的功能饲用添加物,具有重要的理论和应用价值。